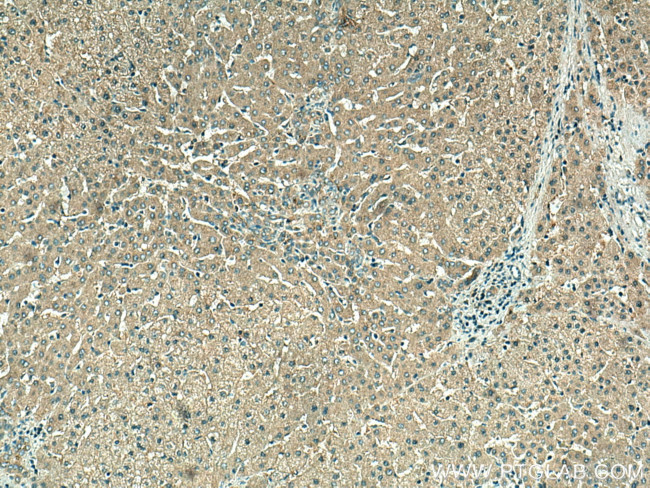
VPS16 Antibody in Immunohistochemistry (Paraffin) (IHC (P))

Search
Proteintech
VPS16 Polyclonal Antibody
{{$productOrderCtrl.translations['antibody.pdp.commerceCard.promotion.promotions']}}
{{$productOrderCtrl.translations['antibody.pdp.commerceCard.promotion.viewpromo']}}
{{$productOrderCtrl.translations['antibody.pdp.commerceCard.promotion.promocode']}}: {{promo.promoCode}} {{promo.promoTitle}} {{promo.promoDescription}}. {{$productOrderCtrl.translations['antibody.pdp.commerceCard.promotion.learnmore']}}
产品信息
17776-1-AP
种属反应
已发表种属
宿主/亚型
分类
类型
抗原
偶联物
形式
浓度
规格
纯化类型
保存液
内含物
保存条件
运输条件
产品详细信息
Immunogen sequence: KVQQKDVSD EDVARAINQK LGDTPGVSYS DIAARAYGCG RTELAIKLLE YEPRSGEQVP LLLKMKRSKL ALSKAIESGD TDLVFTVLLH LKNELNRGDF FMTLRNQPMA LSLYRQFCKH QELETLKDLY NQDDNHQELG SFHIRASYAA EERIEGRVAA LQTAADAFYK AKNEFAAKAT EDQMRLLRLQ RRLEDELGGQ FLDLSLHDTV TTLILGGHNK RAEQLARDFR IPDKRLWWLK LTALADLEDW EELEKFSKSK KSPIGYLPFV EICMKQHNKY EAKKYASRVG PEQKVKALLL VGDVAQAADV AIEHRNEAEL SLVLSHCTGA TDGATADKIQ RARAQAQKK (177-525 aa encoded by BC073959)
靶标信息
Vesicle mediated protein sorting plays an important role in segregation of intracellular molecules into distinct organelles. Genetic studies in yeast have identified more than 40 vacuolar protein sorting (VPS) genes involved in vesicle transport to vacuoles. This gene encodes the human homolog of yeast class C Vps16 protein. The mammalian class C Vps proteins are predominantly associated with late endosomes/lysosomes, and like their yeast counterparts, may mediate vesicle trafficking steps in the endosome/lysosome pathway. Two transcript variants encoding different isoforms have been found for this gene. [provided by RefSeq, Jul 2009]
仅用于科研。不用于诊断过程。未经明确授权不得转售。
生物信息学
蛋白别名: hVPS16; mVPS16; RP11-12M19.2; unnamed protein product; vacuolar protein sorting 16 homolog; vacuolar protein sorting protein 16; Vacuolar protein sorting-associated protein 16 homolog; VPS16, CORVET/HOPS core subunit
基因别名: 1810074M16Rik; DYT30; hVPS16; VPS16
UniProt ID: (Human) Q9H269
Entrez Gene ID: (Human) 64601, (Mouse) 80743, (Rat) 296159